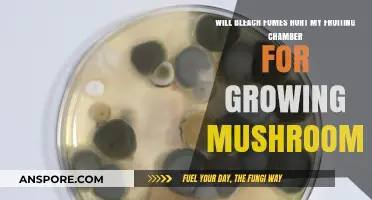
Bleach Fumes and Mushroom Fruiting Chambers: Potential Risks Explained

Luminous Lucy mushrooms, known for their bioluminescent properties, have captivated both mycologists and hobbyists alike, sparking interest in their cultivation. One of the key questions for growers is whether these fascinating fungi will thrive on a BRF (brown rice flour) substrate recipe, a popular and cost-effective medium for mushroom cultivation. BRF substrates are renowned for their nutrient density and ease of preparation, making them an attractive option for cultivating various mushroom species. However, the specific requirements of Luminous Lucy mushrooms, including their need for particular nutrients and environmental conditions, raise questions about the compatibility of BRF substrates with their growth. Exploring this topic involves examining the composition of BRF recipes, the unique needs of Luminous Lucy mushrooms, and potential modifications to optimize the substrate for successful cultivation.
Explore related products
What You'll Learn

BRF substrate preparation steps
To prepare a BRF (brown rice flour) substrate for growing Luminous Lucy mushrooms, begin by gathering high-quality ingredients. The primary components include brown rice flour, vermiculite, and gypsum. Brown rice flour serves as the carbohydrate source, vermiculite helps retain moisture, and gypsum provides essential calcium and prevents substrate compaction. Ensure all materials are clean and free from contaminants to avoid introducing unwanted microorganisms. Sterilization of tools and containers is also crucial to maintain a sterile environment.
The first step in the preparation process is to measure the ingredients accurately. A common ratio for BRF substrate is 5 parts brown rice flour, 3 parts vermiculite, and 1 part gypsum by volume. Mix these dry ingredients thoroughly in a clean, large container to ensure even distribution. Proper mixing is essential to create a homogeneous substrate that supports mycelial growth. Once mixed, the dry substrate is ready for hydration and pasteurization.
Hydration is the next critical step. Boil water and allow it to cool slightly before adding it to the dry mixture. The goal is to achieve a moisture level of approximately 60-70%. Gradually pour the water into the dry substrate while stirring to avoid clumping. The mixture should feel like a wrung-out sponge—moist but not soggy. Overhydration can lead to anaerobic conditions, while underhydration may hinder mycelial colonization.
After hydration, pasteurization is necessary to eliminate competing organisms. Place the substrate in a large pot or steamer and heat it to around 160-180°F (71-82°C) for 1-2 hours. Maintain this temperature range to kill contaminants without damaging the substrate’s nutritional value. Alternatively, some growers use a pressure cooker for sterilization, but pasteurization is often sufficient for BRF substrates. Allow the substrate to cool to room temperature before proceeding.
Once cooled, the substrate is ready for inoculation. Transfer it into sterilized grow bags or jars, leaving enough headspace for the mycelium to colonize. Seal the containers properly to maintain a sterile environment. Introduce the Luminous Lucy mushroom spawn, ensuring even distribution throughout the substrate. Properly prepared BRF substrate provides an ideal medium for mycelial growth, setting the stage for a successful harvest of bioluminescent mushrooms.
Finally, maintain optimal conditions during incubation. Keep the substrate in a dark, warm environment with temperatures between 70-75°F (21-24°C). Regularly monitor for signs of contamination and ensure proper humidity levels. With patience and care, the BRF substrate will support robust mycelial growth, leading to the development of Luminous Lucy mushrooms known for their unique bioluminescent properties.
Exploring California's Mushroom Habitats: Where and When to Find Them
You may want to see also

Optimal conditions for luminous Lucy growth
Luminous Lucy mushrooms, scientifically known as *Mycena lux-coeli*, are bioluminescent fungi that require specific conditions to thrive. When cultivating them on a BRF (brown rice flour) substrate, it’s essential to replicate their natural environment as closely as possible. The BRF substrate recipe is a popular choice due to its nutrient-rich composition, which supports mycelial growth and fruiting. To begin, the substrate should be prepared by combining brown rice flour, vermiculite, and water in a ratio that ensures proper moisture retention and aeration. Sterilization is critical to prevent contamination, as Luminous Lucys are sensitive to competing microorganisms. Pressure cooking the substrate at 15 PSI for 60-90 minutes is recommended to eliminate any unwanted bacteria or molds.
Environmental Parameters
Optimal growth of Luminous Lucy mushrooms hinges on maintaining precise environmental conditions. Temperature plays a pivotal role, with the ideal range for mycelial colonization being 70-75°F (21-24°C). Once fruiting begins, slightly cooler temperatures of 65-70°F (18-21°C) encourage the development of healthy, bioluminescent caps. Humidity levels are equally crucial, as these mushrooms require a high-humidity environment, ideally between 90-95%. This can be achieved by misting the growing area regularly or using a humidifier. Proper air exchange is also essential to prevent CO2 buildup, which can inhibit growth. A still air box or a grow tent with passive airflow works well for maintaining these conditions.
Lighting and Darkness
Luminous Lucys are unique in their bioluminescent properties, which are influenced by light exposure. While they do not require light for photosynthesis, a brief period of indirect light (12 hours) followed by complete darkness (12 hours) can enhance their glow. However, prolonged exposure to direct light can stress the mushrooms and reduce their luminosity. The darkness phase is particularly important, as it triggers the production of luciferin, the compound responsible for their glow. For optimal bioluminescence, ensure the growing area is completely dark during the night cycle, using light-blocking materials if necessary.
Substrate Maintenance and Fruiting
After inoculating the sterilized BRF substrate with Luminous Lucy spawn, it’s crucial to monitor the colonization process. Mycelium should fully colonize the substrate within 2-3 weeks under optimal conditions. Once colonization is complete, initiate fruiting by introducing fresh air and maintaining the cooler temperature range. Mist the substrate lightly to prevent drying, but avoid overwatering, as excess moisture can lead to mold or bacterial growth. Fruiting bodies typically appear within 7-14 days after the fruiting conditions are established. Harvest the mushrooms when the caps are fully open but before they begin to release spores to ensure the best bioluminescent display.
Troubleshooting Common Issues
Cultivating Luminous Lucys on BRF substrate can present challenges, such as contamination or poor fruiting. To minimize contamination, always work in a sterile environment and use proper sterilization techniques. If mold appears, it’s often a sign of improper sterilization or excessive moisture. Adjusting humidity levels and ensuring adequate airflow can prevent this issue. Poor fruiting may result from incorrect temperature or light conditions, so double-check that the environment aligns with the mushrooms’ needs. Patience is key, as Luminous Lucys may take longer to fruit compared to other species. With careful attention to these optimal conditions, successful cultivation of bioluminescent Luminous Lucy mushrooms on BRF substrate is achievable.
Penis Envy Mushrooms: Visual Growth Stages and Identification Guide
You may want to see also

Sterilization techniques for BRF substrate
When preparing BRF (brown rice flour) substrate for growing luminous Lucy mushrooms (or any other mushroom species), sterilization is a critical step to ensure the substrate is free from contaminants that could compete with or harm the mycelium. Proper sterilization techniques create a clean environment for the mushroom mycelium to colonize the substrate without interference from bacteria, molds, or other fungi. Below are detailed methods and instructions for sterilizing BRF substrate effectively.
Pressure Cooking: The Most Reliable Method
The most common and effective sterilization technique for BRF substrate is using a pressure cooker. This method ensures that the substrate reaches and maintains a temperature high enough to kill all contaminants. To sterilize, first prepare your BRF substrate by mixing it with water to achieve a moisture content of around 60-70%. Pack the substrate into autoclavable bags or jars, leaving enough headspace to allow for expansion during sterilization. Seal the bags or jars loosely to prevent explosion, then place them in the pressure cooker. For optimal results, process the substrate at 15 PSI (pounds per square inch) for 60-90 minutes. This duration ensures that the heat penetrates the substrate thoroughly, eliminating all unwanted microorganisms. After sterilization, allow the pressure cooker to cool naturally to avoid contamination during opening.
Steam Sterilization: An Alternative Approach
If a pressure cooker is unavailable, steam sterilization can be used as an alternative, though it is less reliable for dense substrates like BRF. To steam sterilize, place the substrate-filled containers in a large pot or steamer with a rack at the bottom. Add water to the pot, ensuring it does not touch the substrate containers. Cover the pot and bring the water to a rolling boil, maintaining the temperature for at least 1.5 to 2 hours. While this method can work, it is less consistent than pressure cooking because steam may not penetrate the substrate as effectively, leaving potential pockets of contamination.
Chemical Sterilization: A Last Resort
Chemical sterilization using agents like hydrogen peroxide or bleach is generally not recommended for BRF substrate due to the risk of chemical residues affecting mycelial growth. However, if no other methods are available, a 10% bleach solution can be used to sterilize tools and containers, but not the substrate itself. For substrate, hydrogen peroxide (3%) can be mixed into the BRF before incubation, but this method is inconsistent and may inhibit mycelial growth. Chemical sterilization should only be considered as a last resort and is not ideal for ensuring a clean substrate.
Post-Sterilization Handling
After sterilization, it is crucial to handle the substrate with care to maintain its sterile condition. Allow the substrate to cool to a temperature that is safe for inoculation (around 70-80°F or 21-27°C) before introducing the mushroom spawn. Work in a clean environment, preferably a still air box or laminar flow hood, to minimize the risk of airborne contaminants. Once inoculated, seal the substrate containers properly and incubate them in a dark, temperature-controlled environment to promote mycelial colonization.
Troubleshooting Common Issues
If contamination occurs despite sterilization, it may be due to improper sealing of containers, insufficient sterilization time, or inadequate cooling procedures. Always inspect the substrate for signs of contamination before inoculation, such as discoloration or unusual odors. If contamination is detected, discard the affected substrate and sterilize new batches, ensuring all equipment and tools are thoroughly cleaned and sterilized before reuse. Consistent attention to detail during the sterilization process is key to successful mushroom cultivation on BRF substrate.
Cultivating Psychedelic Mushrooms: A Beginner's Guide to Indoor Growing
You may want to see also
Explore related products

Common contaminants to avoid in BRF
When cultivating Luminous Lucy mushrooms (or any other mushroom species) on a BRF (brown rice flour) substrate, maintaining a sterile environment is crucial to prevent contamination. Contaminants can quickly overtake your substrate, ruining your harvest. Here are some common contaminants to be vigilant about:
Mold: This is perhaps the most prevalent issue in mushroom cultivation. Various mold species, such as Trichoderma and Aspergillus, can rapidly colonize your substrate, forming fuzzy patches of green, black, or white growth. Mold spores are ubiquitous in the environment, and they can enter your growing area through the air, on tools, or even on the substrate ingredients. To prevent mold, ensure all equipment is sterilized, and consider using a still air box or laminar flow hood when working with exposed substrate.
Bacteria: Bacterial contamination often appears as slimy, discolored patches on the substrate, which may have a foul odor. Bacteria can be introduced through contaminated water, unsterilized tools, or poor hygiene practices. Always use sterilized water for mixing your substrate, and maintain a clean workspace. Wearing gloves and a face mask can also reduce the risk of bacterial contamination.
Yeast: Yeast contamination might look similar to mold, with fuzzy growth, but it often has a more uniform color, typically white or cream. Yeast can produce off-flavors in mushrooms and may indicate that the substrate was not properly pasteurized or sterilized. Ensuring the BRF substrate reaches the correct temperature during preparation is vital to killing yeast and other contaminants.
Nematodes and Insects: These tiny creatures can infest your substrate, feeding on the nutrients meant for your mushrooms. Nematodes are microscopic worms that can be difficult to detect until they've caused significant damage. Insects, such as fruit flies or fungus gnats, may lay eggs in the substrate, leading to an infestation. Sourcing high-quality, fresh ingredients and storing them properly can help prevent these contaminants. Additionally, keeping your growing area clean and free of attractants will discourage insects.
Competing Fungi: Other mushroom species or wild fungi can contaminate your substrate, competing with Luminous Lucy mushrooms for resources. These contaminants might be introduced through spores in the air or on unsterilized equipment. Maintaining a sterile environment and using proper filtration systems can significantly reduce the risk of fungal contamination. Regularly inspecting your substrate during incubation can help identify any unwanted fungal growth early on.
Avoiding these common contaminants requires strict attention to sterilization, hygiene, and environmental control. By implementing these measures, you can create an optimal environment for Luminous Lucy mushrooms to thrive while minimizing the chances of contamination. Remember, successful mushroom cultivation often relies on meticulous attention to detail and maintaining a clean, controlled space.
Identifying Common Lawn Mushrooms: Types, Causes, and Safe Removal Tips
You may want to see also

Harvesting luminous Lucy mushrooms timeline
Harvesting luminous Lucy mushrooms on a BRF (brown rice flour) substrate follows a specific timeline that requires careful monitoring and patience. The process begins with colonization, where the mycelium grows through the substrate, typically taking 7 to 14 days depending on temperature and humidity. During this phase, the substrate will turn white as the mycelium spreads, indicating healthy growth. It’s crucial to maintain sterile conditions during this stage to prevent contamination. Once fully colonized, the substrate is ready for the next phase, which is fruiting.
The fruiting stage begins when the colonized BRF substrate is exposed to proper environmental conditions, such as lower temperatures (around 68–72°F or 20–22°C), higher humidity (85–95%), and a light cycle (12 hours of indirect light and 12 hours of darkness). Within 5 to 7 days, tiny mushroom pins will start to form on the surface of the substrate. These pins are the first visible signs of mushroom growth and will rapidly develop into mature fruiting bodies. During this time, maintaining consistent humidity is critical to prevent the mushrooms from drying out or aborting.
By days 10 to 14 after initiating fruiting conditions, the luminous Lucy mushrooms will reach their full size. They are ready for harvest when the caps are fully open, but the veil underneath has not yet torn. Harvesting at this stage ensures optimal potency and appearance. To harvest, gently twist and pull the mushrooms at the base to avoid damaging the mycelium or the substrate. Proper harvesting technique allows for multiple flushes, as the mycelium can continue to produce new mushrooms.
After the first flush, the substrate may appear spent, but it often retains enough nutrients for additional harvests. To encourage a second flush, rehydrate the substrate by misting it with water and maintaining optimal fruiting conditions. A second flush typically appears within 7 to 14 days after the first harvest, though it may be smaller in size. Subsequent flushes may follow, but yields tend to decrease with each cycle. Monitoring the substrate for signs of contamination or exhaustion is essential to ensure successful multiple harvests.
The entire timeline from inoculation to final harvest can span 4 to 6 weeks, depending on environmental conditions and the vigor of the mycelium. Luminous Lucy mushrooms grown on BRF substrate are known for their bioluminescent properties, which are most pronounced in low-light conditions. Harvesting at the right time not only maximizes yield but also ensures the mushrooms retain their unique glowing characteristics. Consistent care and attention to detail throughout the timeline are key to a successful and rewarding harvest.
Do Oyster Mushrooms Grow on the Ground? Exploring Their Habitat
You may want to see also
Frequently asked questions
Yes, Luminous Lucy mushrooms (a type of glow-in-the-dark mushroom) can grow on a BRF substrate recipe, as it provides the necessary nutrients for mycelium colonization and fruiting.
A common BRF substrate recipe includes a mixture of brown rice flour, vermiculite, and gypsum, supplemented with water to achieve the right moisture level for optimal growth.
Fruiting time varies, but Luminous Lucy mushrooms typically begin to fruit within 2-4 weeks after colonization of the BRF substrate, depending on environmental conditions.
Yes, they require a humid environment (around 90-95% humidity), proper ventilation, and indirect light to stimulate fruiting and maintain their bioluminescent properties.